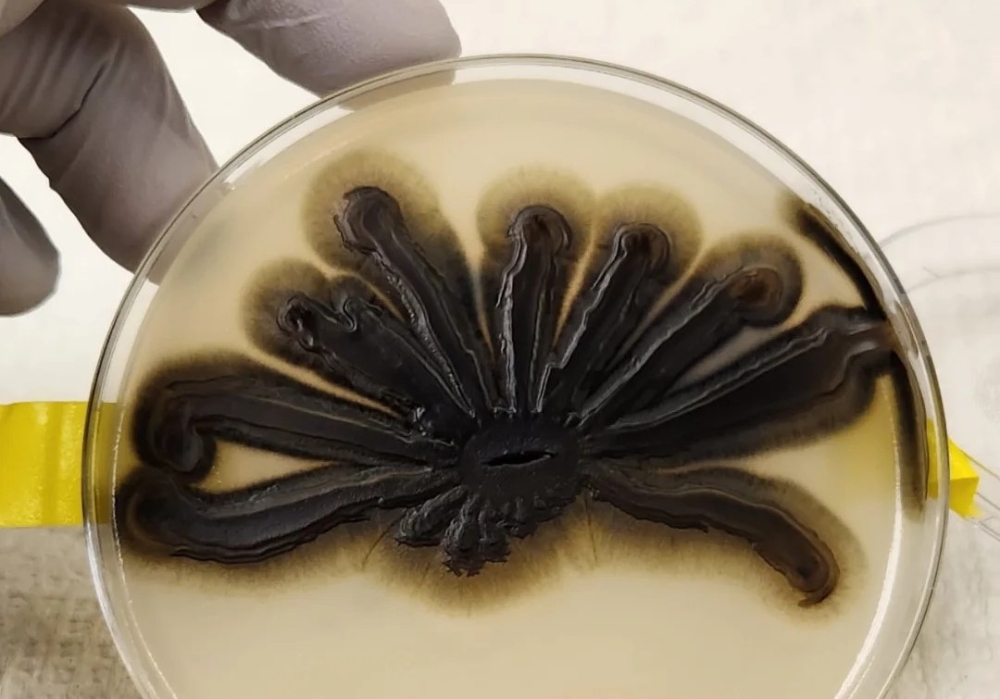
Μαύρος μύκητας μετατρέπει τα πλαστικά απόβλητα σε βρώσιμα συστατικά

Οι μύκητες ίσως είναι η πιο εντυπωσιακή μορφή ζωής στη Γη. Μπορούν να ζήσουν σχεδόν οπουδήποτε, έχουν φαρμακευτικές αλλά και τοξικές ιδιότητες, και όπως δείχνουν νέες μελέτες, είναι ικανοί να μετατρέπουν βιομηχανικά απόβλητα σε χρήσιμες ενώσεις.
Μηχανικοί της γερμανικής νεοσύστατης εταιρείας Biophelion ανέπτυξαν μια καινοτόμο μέθοδο για την επιτυχή αποσύνθεση και μετατροπή πλαστικών αποβλήτων σε νέα προϊόντα, με τη χρήση ενός μαύρου μύκητα που μοιάζει με μαγιά, του Aureobasidium pullulans. Παράλληλα, ο μύκητας αυτός απορροφά το υπόλοιπο διοξείδιο του άνθρακα από τα πλαστικά απόβλητα, χρησιμοποιώντας το για τη θρέψη του αποτρέποντας έτσι την απελευθέρωση του CO2 στην ατμόσφαιρα.
Η δύναμη των μυκήτων
Ωστόσο, ο μύκητας δεν μετατρέπει τα απόβλητα σε ένα βήμα. Αρχικά, ο Aureobasidium pullulans- ένας ανθεκτικός μύκητας που μπορεί να ζήσει παντού, να φάει οτιδήποτε και να παράγει διάφορες ενώσεις- καταναλώνει τα βιομηχανικά υποπροϊόντα. Το πεπτικό του σύστημα τελικά αποβάλλει τα απόβλητα με τη μορφή τριών ενώσεων που είναι κρίσιμες για την παραγωγή νέων, χρήσιμων υλικών.
Σύμφωνα με τους ερευνητές, αυτές οι ενώσεις περιλαμβάνουν την πουλουλάνη (pullulan) ένα άγευστο και βρώσιμο πολυμερές που χρησιμοποιείται ήδη στην παραγωγή τροφίμων, έναν πολυεστέρα κατάλληλο για πλαστικές συσκευασίες και ένα λιγότερο γνωστό μόριο επιφανειοδραστικής ουσίας, το οποίο η ομάδα θέλει να χρησιμοποιήσει στην τρισδιάστατη εκτύπωση.
Όσον αφορά τις βρώσιμες εφαρμογές, η πουλουλάνη χρησιμοποιείται ως πρόσθετο τροφίμων για να προσδώσει όγκο και υφή σε βρώσιμα φιλμ που χρησιμοποιούνται σε τσίχλες, αλλά και για την παρασκευή χαπιών κατάλληλων για χορτοφάγους. Η ομάδα εξακολουθεί να μελετά τους ακριβείς μηχανισμούς αυτής της διαδικασίας, αλλά ελπίζει ότι ανακάλυψε κάτι συναρπαστικό.
Φυσικές λύσεις για την αντιμετώπιση της ρύπανσης
Ο χρόνος θα δείξει εάν η τεχνολογία της εταιρείας μπορεί να αποτελέσει το επόμενο μεγάλο βήμα στη επιστήμη των υλικών. Η μέθοδος, όπως είναι τώρα, προσφέρει ήδη μια δελεαστική λύση για τα πλαστικά απόβλητα. Η διαδικασία έχει σχεδιαστεί ώστε να είναι βιώσιμη και φιλική προς το περιβάλλον.
Το μόριο επιφανειοδραστικής ουσίας, ειδικότερα, θα μπορούσε να αποτελέσει τον ιδανικό αντικαταστάτη των τεχνητών επιφανειοδραστικών ουσιών- χημικών ουσιών που παράγονται μαζικά και χρησιμοποιούνται σε απορρυπαντικά ρούχων και πιάτων και οι οποίες ρυπαίνουν το περιβάλλον. Οι ερευνητές δηλώνουν ενθουσιασμένοι που η τεχνολογία τους μπορεί να συμβάλει στην αντιμετώπιση ορισμένων από τα πιο επείγοντα προβλήματα του σύγχρονου κόσμου.
«Συχνά υπάρχει ένα χάσμα μεταξύ της ακαδημαϊκής έρευνας και της βιομηχανικής εφαρμογής», δήλωσε ο Τιλ Τίσο, συνιδρυτής της Biophelion και μικροβιολόγος στο Πανεπιστήμιο Bielefeld στη Γερμανία. «Αλλά αυτή τη φορά τα πράγματα είναι διαφορετικά. Εδώ μπορούμε να κάνουμε μόνοι μας το άλμα από την ακαδημαϊκή έρευνα στην βιομηχανική εφαρμογή» κατέληξε.


















































